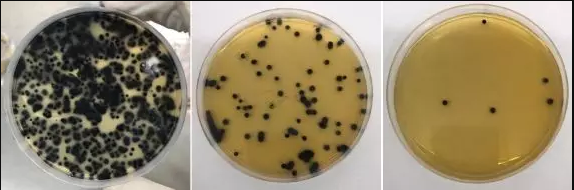
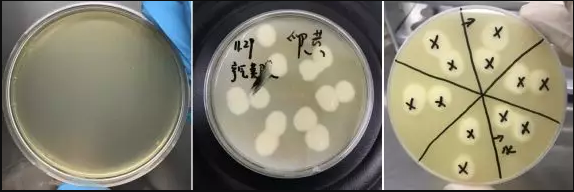
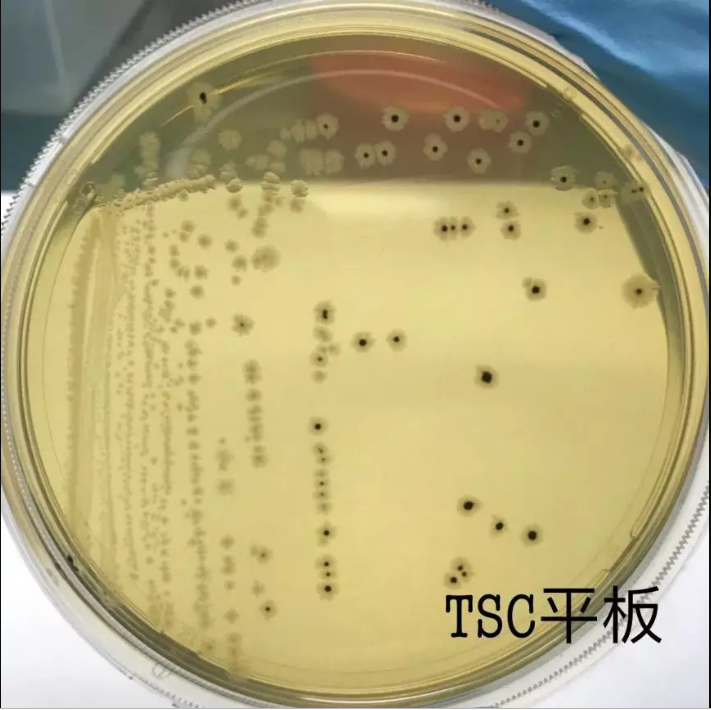
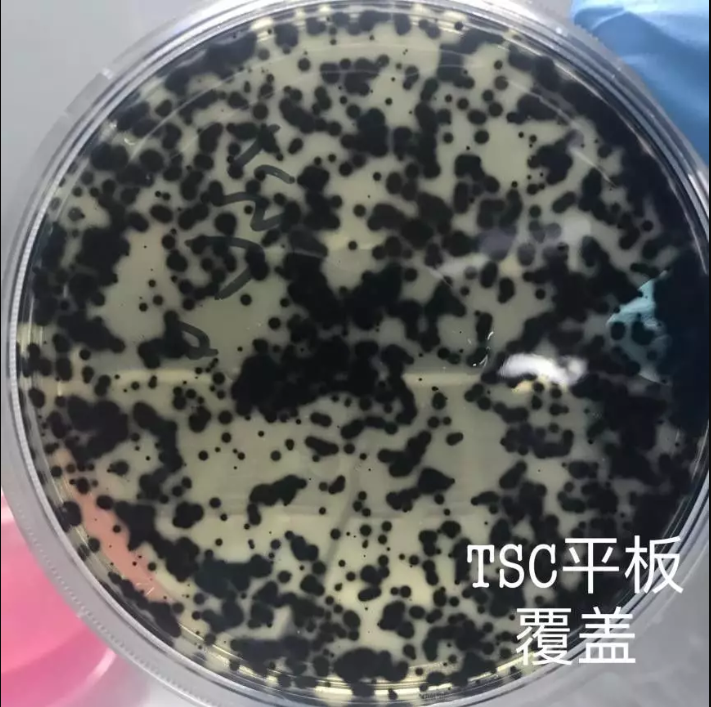

海博微信公众号
海博微信公众号
 海博天猫旗舰店
海博天猫旗舰店


 海博微信公众号
海博微信公众号
 海博天猫旗舰店
海博天猫旗舰店





一次关于利用产气荚膜梭菌进行2个国标检测的方法证实过程及其收获
作者:菩提
编辑:兔兔子
来源:实验助手app
特别鸣谢:青岛海博生物
1.前言
(一)为什么要检测产气荚膜梭菌?
因为这个菌是条件致病菌,时不时跳出来害人。产气荚膜梭菌是条件致病菌,最大的特点是快速分解肌肉和结缔组织里的糖,产生大量气体(暴烈发酵实验可证明),造成肿胀和致病(主要有坏疽病)。条件致病菌是个啥东西?就是能让你得病,但有条件:条件1:免疫缺陷或免疫力低下的人容易感染。有免疫力的人可以带着这个菌到处乱跑,没事。跑着跑着遇到一个免疫力缺陷或免疫力低(老、弱、病)的人,把菌给了对方,那被接触的朋友就比较惨。

条件2:菌去了不该去的地方。比如产气荚膜梭菌在肠道里过的好好地,结果去了受伤的肌肉或结缔组织,那么菌就要吃肉,人就要生病了。
条件3:满足任意条件1或条件2都可能致病。

(二)产气荚膜梭菌检测方法建立意义
除了是条件致病菌外,产气荚膜梭菌种下不同菌株产毒能力也各不相同,加起来能生产15种以上毒素,其中以ABCDE五种毒素最为典型。产气荚膜梭菌检测方法建立的意义还在于产气荚膜梭菌广泛存在在自然界中,范围广兄弟多,所以容易被它污染;产气荚膜梭菌感染人的方式主要是菌从口入,病从口入,所以产气荚膜梭菌是食源性的条件致病菌。
当然这是国家制定标准要考虑的事情,我们知道检测方法建立很有意义就好了。作为检测人员,我们更重要的关心是怎么做好实验,让实验方法运用的更为流畅,有时候有一定微生物学基础的可能会好些,但就目前国情,从事微生物检测的还有许多正在努力学习提高的非微生物学专业的技术人员,所以我们检测人员更重要的是要知道每一步检测的目的以及为什么这么做,当检测出现疑惑或和检测标准出现不符时候该怎么解决更有意义。
(三)产气荚膜梭菌检测方法比较
鸿蒙初开,这世上本无对错,自从有了标准和比较就有了优劣的分别。
挑选的2个现行有效国标,其一为:GB 4789.13-2012《食品安全国家标准食品微生物学检验 产气荚膜梭菌检验》。(以下简写,用标准号“GB 4789.13-2012”代替标准全名);其二为:GB 8538-2016《食品安全国家标准饮用天然矿泉水检验方法》58产气荚膜梭菌。(以下简写,用“GB 8538-2016.58”代替标准对应产气荚膜梭菌检测项目)。
产气荚膜梭菌检测方法有许多,挑选这2个标准进行方法学比较。是因为这2个标准使用的比较多,也是我最近扩项用到的,所以更熟悉一些。二个标准适用范围有所不同,GB 4789.13-2012适用于食品,GB 8538-2016适用于饮用天然矿泉水,除却GB 4789.13-201倾注平板方法和GB 8538-2016过滤水样外,其他检测部分其实是相似和可以相互参考和比较优劣长短之分的。不影响方法的比较和探索。
2.产气荚膜梭菌的分类学地位

产气荚膜梭菌顾名思义能产气,有荚膜,是梭菌。这也是最初科学家定名时候的特点,这样的好处在于名字就带了菌的特色,特点鲜明(当然只是中文名有这个特点)。产气荚膜梭菌拉丁学名叫Clostridium perfringens,目前所有的细菌拉丁文学名均被微生物权威分类学手册“伯杰氏手册”(伯杰氏系统细菌学手册,Berger’s Manual of Systermatic Bacteriology)收录。
简单介绍一下伯杰氏手册。伯杰氏手册已经发展到第9版了,前8版国内基本都有中文版。第9版国内较少,这不利于微生物学发展,特意放出伯杰氏手册英文版封面(下图)供大家参考。伯杰手册第9版共5卷7册(纸质版加起来重达15公斤):
卷1:古细菌和深分支菌及光合细菌,
卷2:变形杆菌(三册)A册导论,B册γ(读音gamma)-变形杆菌,C册(α-,β-,δ-,ε-变形杆菌),
卷3:卷3厚壁菌门,
卷4:(拟杆菌, Spirochaetes螺旋体门, Tenericutes (Mollicutes)无壁菌门(柔壁菌门),Acidobacteria酸杆菌门, Fibrobacteres纤维杆菌门, Fusobacteria梭菌属, Dictyoglomi网团菌门, Gemmatimonadetes芽单孢菌门, Lentisphaerae黏胶球形菌门),
卷5(到目前为止总共才出到5卷A册):A册放线菌门。

产气荚膜梭菌发现比伯杰氏手册的创立早,所以当时世界各国发现这个菌的科学家命名时就根据自己的意愿起名字(未约定俗成,也无什么特定规则),1898年Veillon和Zuber发现时叫做“产气荚膜杆菌(Bacillus perfringens)”,在另外一个地方,1900年Migula发现并把它叫做“魏氏细菌(Bacterium welchii)”。在1980年世界上又召开了一次细菌学大会,对菌种命名进行了统一,对于以前的各种菌归到一个清单里(Lists 1980),产气荚膜梭菌也在其中。定名为:产气荚膜梭菌,全名叫:“Clostridium perfringens (Veillon and Zuber 1898) Hauduroy et al.1937,species.”,这一套规则是为了保证其唯一性也为了纪念发现的科学家,规则不难看出就是:拉丁文属名(斜体字)_拉丁文种名(斜体字)_发现人名_发现年_分类学位置(比如种),“_”表示用空格隔开,此后再有谁发现了新种以及随着时间和认识的变化要进行合并更改都需要依照一套严格的规则进行。
所以产气荚膜梭菌在分类学地位上面是“种”(species),隶属于厚壁菌门梭状芽孢杆菌属。菌体特点是革兰氏阳性杆菌,菌体粗大,二端钝圆,体内可形成芽孢。有荚膜,无鞭毛,厌氧生长。

图2:产气夹膜梭菌革兰氏染色镜检观察
芽孢是抗逆环境的产物,生存环境变恶劣时芽孢菌才会产生芽孢。2个国标方法中不易看到芽孢,主要是因为:
(1)标准提供的TSC和SPS培养基营养较好,
(2)20-24h就观察结果,时间较短,还未形成。
产气荚膜梭菌产生芽孢的特点是产生芽孢时菌体不会膨大,芽孢形成在菌体中部。
3.实验材料准备
(一)设备及材料准备
1.配培养基所用设备:
(1)天平(百分之一以上天平,),
(2)纯水机(制备培养基配制用水,或用蒸馏水机制备蒸馏水),
(3)高压蒸汽灭菌器,
2.前处理设备:
(1)天平(百分之一以上天平,称取食品样品用,略),
(2)均质器(拍打式均质器),
(3)旋涡混匀仪(遇到不少人不配备混匀仪,习惯用手振摇。建议使用混匀仪,定量实验,以免手振摇不均匀带来风险。)
3.操作设备:
(1)超净台(略),
(2)2级生物安全柜,
(3)三联过滤器(过滤水样),
4.培养材料及设备:
产气荚膜梭菌是厌氧菌,在厌氧环境种生长良好。常用的培养方法有:厌氧产气袋法、厌氧罐法、厌氧盒、厌氧手套箱等。
为了比较实验,我做实验时准备了以下设备。
(1)厌氧袋(配套氧气指示剂、厌氧产气袋。厌氧产气袋有时也叫厌氧包或培养袋),
(2)厌氧培养盒(配套氧气指示剂、厌氧产气袋),
(3)厌氧操作箱(也叫手套箱,配气制造厌氧环境),
(4)三气培养箱(CO2,N2,O2),
(5)普通培养箱(用于厌氧产气袋和厌氧盒的存放培养装置)。

(二)培养基和试剂:
1. 0.1%蛋白胨水,
2.胰胨-亚硫酸盐-环丝氨酸琼脂(TSC),(添加剂D-环丝氨酸);
3.亚硫酸钠盐-多粘菌素-磺胺嘧啶琼脂基础(SPS添加剂)
4.液体硫乙醇酸盐培养基(FTG),
5.含铁牛奶培养基,
6.缓冲-动力硝酸盐(硝酸盐还原试剂,锌粉),买成品试剂盒验收后使用,方便。
7.乳糖-明胶培养基,
8.卵黄琼脂培养基。
4.标准菌株准备
(警告:从标准菌株开始都需要在生物安全柜里正确操作,并注意个人防护)
(一)本单位使用的阳性对照菌株:产气荚膜梭菌CICC22949。
本单位使用的阴性对照菌株:艰难梭菌CICC22951。
(二)标准菌株的选择。
标准菌株的选择以美国机构ATCC最为出名,但也不是他一家独大,因为伯杰手册明确规定了,只有一家存有的标准菌株不被承认,也就是说国际上当某一个人或机构发现了一个新种时,必须同时送往2家被认可的机构保藏,这个新种才会被国际社会承认。这也是为了反垄断,有时候一株菌拥有巨大的商业利益,一家私藏,不利于微生物学科的发展。
所以作为我们,可能知道的最出名的就是菌种保藏中心也就是美国的ATCC机构了,但是,不是美国ATCC一家独大。“伯杰氏手册”列举了被承认的机构的标准菌株信息,只要纸质材料能溯源到这几家单位其中之一即可。
(三)伯杰手册推荐的关于产气荚膜梭菌标准标准菌株信息。
我把手册中关于我们这次产气荚膜梭菌检验实验用得到的阳性对照菌和阴性对照菌信息摘录如下:
1.阳性对照菌株:
(1)产气荚膜梭菌,Clostridium perfringens,“Type strain: ATCC 13124= BCRC (formerly CCRC) 10913 = CCUG 1795 = CIP 103409 = DSM 756 = JCM 1290 = LMG 11264 = NCAIM B.01417 = NCCB 89165 = NCIMB 6125 = NCTC 8237”。(参考:我单位所选产气荚膜梭菌CICC22949,可溯源到ATCC13124)。
2.阴性对照菌株:严格厌氧菌(任选其一即可)。
(2)艰难梭菌Clostridioides difficile,Type strain: AS 1.2184 = ATCC 9689= BCRC (formerly CCRC) 10642 = CCUG 4938 = CIP 104282 = DSM 1296 = JCM 1296 = LMG 15861 = NCIMB 10666 = NCTC 11209。(我单位所选艰难梭菌CICC22951,可溯源到ATCC43593)。
(3)生孢梭菌Clostridium sporogenes,Type strain: ATCC 3584= BCRC (formerly CCRC) 11259 = CCUG 15941 = CIP 106155 = DSM 795 = JCM 1416 = LMG 8421 = NCIMB 10696 = NCTC 13020.
其中国家食品药品监督管理总局科技和标准司编著的《微生物检验方法 食品安全国家标准 实操指南》(中国医药科技出版社2017.10)版本第143页图13.6乳糖-明胶液化实验中生孢梭菌的编号有误,ATCC64941应改成CMCC64941,大家注意一下。别真买成了ATCC64941,那是Cryptococcus neoformans菌。
(4)索氏梭菌Clostridium sordellii,Type strain: ATCC 9714= BCRC (formerly CCRC) 10649 = CCUG 9284 = CIP 103658 = DSM 2141 = JCM 3814 = LMG 15708 = NCIMB 10717。

(参考:我单位所用的标准菌株均有标准菌株证书,可溯源到上述国际单位,购买回来后均进行了技术验收,合格后投入使用;使用前登记造册,编制菌株的唯一性顺序号。每次使用周期性(一月一次)验收,并继续完善记录并都详细记录在册。保证菌株从买到手,技术验收,传代,使用直至销毁均可溯源,同时保证菌株性能在使用期限内是有效的。
如果其他单位要购买(或已经购买了)标准菌株,需核查菌株信息,要有材料能证明其可溯源到以上我列举的国际单位,同时也要做好菌株管理工作。)
5.实验操作
在看我写这部分之前,建议大家把GB4789.13-2012和GB 8538-2016.58都分别读一下,不然有可能有地方看不明白。

图:几种产气荚膜梭菌培养基@青岛海博
(一)培养基制备
1. 0.1%蛋白胨水、TSC,SPS配制。
在配制培养基过程中,TSC和SPS做真实样品时添加添加剂以抑制杂菌,模拟实验没有添加(添加剂价格不菲)。
TSC和SPS培养基脱水合成培养基基础的模样(添加剂另配)

2. FTG培养基配制。
FTG需增加少量琼脂。加琼脂主要是怕液体流动回流,厌氧环境被破坏。不同意见:实际过程中我加和不加都做过,最初不加是因为忘记了:(。如果动作轻缓,管内FTG较长,不加琼脂也不影响菌的繁殖生长,注意观察会发现,不加琼脂时,管子放到厌氧盒内很快就能变黄(厌氧状态)。
FTG灭菌完成后注意放在厌氧条件下(比如厌氧盒或厌氧操作箱),这样可以使氧化层下行较慢。如果没有条件就临时煮沸赶气。等再变成浅黄色包裹紧管口,阻止氧气进入。经过反复几次实验,18*180管中配制15mL以上为宜(我一般配20mL)。
FTG刚配出来时样子和灭菌后样子(有1管塞子崩了,量变少了)

FTG灭菌后↑

FTG灭菌前↑
3.含铁牛奶培养基的配制。
这个培养基建议不要用脱水合成成品培养基。而购买全脂鲜牛奶加硫酸亚铁。灭菌温度最好选用115℃,5min,试管放在灭菌锅里的位置远离加热管及内壁,以免瞬间过热变性絮凝。灭完菌及早取出,急速冷水速冷却。
配制含铁牛奶培养基折腾我不少时间,首先就是商品化脱水培养基并不好使,所以我特意去买新鲜未脱脂的牛奶,然后添加完硫酸亚铁,混匀后灭菌。第一次115℃,10min,失败。蛋白质絮凝变性了。设定这个温度时长是根据GB 8538-2016来的,同时加上我们灭菌锅校准温度点有115℃。痛定思痛,分析问题,找失败原因。分析出3个可能原因:
(1)和牛奶有关。
(2)和灭菌锅内放置位置有关。
(3)灭菌时长有关。
找出原因捋起袖子加油干,去市场买了好几种全脂牛奶,然后配成培养基,量不变。
在灭菌锅内不同位置(三层,每次2个,框中心1个,边上1个)放置培养基,115℃10min灭菌;另一批次115℃,5min灭菌。灭菌完马上取出自来水急速冷却。实验后现象是:115℃,5min的均正常,没絮凝。115℃,10min的时有絮凝。同时发现较贵的牛奶絮凝的少或没有絮凝。培养一周,无菌生长,证明了115℃,5min可灭菌,满足实验要求。



4.缓冲-动力硝酸盐培养基,乳糖-明胶培养基,买的成品试剂盒,卵黄琼脂培养基按要求配置没有问题。
(二)样品处理
1.固体样品处理。冷藏冷冻样品提前拿出来按要求化冻。
固体样品称取25g±0.1g样品,放入均质袋,加入225mL预先灭菌好的稀释液,均质1min或2mins(我们内部规定2mins),然后进行10倍稀释梯度稀释。
2.液体食品样品处理。
液体样品GB4789.13-2012上没提,根据GB 4789系列其他标准稀释就好了,比如25mL加入225mL预先加了一些玻璃珠的灭好的稀释液,混匀打散,然后进行10倍稀释梯度稀释。也可以用均质袋均质(均质就不要加玻璃珠了)。
3.天然饮用矿泉水样品处理。
过滤法,混匀水样。配备0.1%蛋白胨水,用于过滤后冲洗过滤设备。
4.关于食品样品用的稀释液选择问题。
我们做检测时候一般用的稀释液主要有四种:纯水,0.85%生理盐水,磷酸盐缓冲溶液,蛋白胨水。有时候有人问稀释液怎么选择,个人理解是这样的:只要能有利于样品中的菌活下来就是好的稀释液。所以如果知道产品的生产过程,知道菌都经历了什么,就可以更好的选择合适的稀释液,如果不知道过程,那我们就要知道四种稀释液的各有什么优点,方便自己选择。
(1)纯水没有缓冲能力,受伤的菌可能会活不过来。
(2)0.85%生理盐水,一般菌都适宜,氯化钠是细胞膜钠-钾泵的钠主要的提供者,同时0.85%这个浓度能平衡胞内胞外渗透压,所以对菌是有利的。
(3)磷酸盐缓冲溶液、优点就是包容性好,缓冲能力强,能让菌在酸碱中起到一个保护作用,而不会因酸碱引起的波动造成菌二次伤害或死亡,当然这也是相对的,样品过酸过碱需要调节pH至中性左右为宜。
(4)蛋白胨水,又比以上稀释液要好,因为里面提供了一定的蛋白胨营养物质,有利于濒死细菌的缓活过来。
当然了,缓冲溶液绝不止这4种,如果想要更好的又有营养又有缓冲能力,也是可以复配出更好的稀释液的。凡事都要讲究性价比,这个方法里面选择0.1%蛋白胨水已能满足要求。
(三)稀释
全程用标准菌株代替样品,所以稀释的就是标准菌株的稀释,从预先长好的菌苔,取1接种环培养好的菌株,加入9mL蛋白胨水里打散,混匀,比对0.5麦氏比浊管,差不多就可以认为此为10的8次方菌液(概数,因为后续会有好几个稀释度保证有符合要求的菌落数可以计数,所以不必担心浓度偏差了)。此设为菌液原液,然后按照10倍梯度稀释制成10-1~10-6系列稀释液。
二个方法的稀释液均用此系列稀释液稀释液进行实验。
(四)倒皿
1. GB4789.13-2012采用倾倒法,取1mL菌液,加入无菌皿中,倾注TSC琼脂培养基,混匀,冷却,每稀释度2皿,10-1~10-6共计14皿(带2个空白,稀释液用1mL0.1蛋白胨水)。同时用SPS倾注一份,作为对比使用,冷却后覆盖同样的培养基5-10mL。
2. GB 8538-2016采用倾注法和过滤法同时进行。倾注法同GB4789.13-2012,只是倾注培养基用的是SPS。过滤法,取1mL水样加入50mL预先灭好的0.1mL蛋白胨水中,混匀后过滤,做2份,滤膜贴TSC和SPS培养基上培养。
(五)培养
将以上平板放到厌氧产气袋中,弄好指示剂以及放好产气包,36℃正置培养24h,然后取出观察。
(六)结果讨论
通过实验发现,覆盖了培养基的产气荚膜梭菌为黑色,没有覆盖的则不变黑,另外TSC比SPS上菌数量更多。也更黑,随着时间的推移,TSC上菌变大速度比SPS更快,所以皿更黑。超过24h后如果菌较多则会有部分交替蔓延,不易记数,有时候SPS上菌还会不黑呈现灰白色。
TSC培养基上产气荚膜梭菌样子(倾倒法,表面覆盖培养基后)(高稀释度,低稀释度): 黑色明显,且24h较大,建议20h开始计数。

SPS上菌落样子(倾倒法,表面覆盖培养基后)(高稀释度,低稀释度):灰黑色,黑色不明显
后续各种生化验证实验(动力试验,镜检,硝酸盐还原,暴烈发酵,,乳糖明胶试验,卵磷脂分解试验等)。由于本次菌为已知标准菌株,所以验证就变成了验证培养基性能了。
6.一些后续实验及经验总结
分享多次试验后获取的一些经验(其实都是拿失败换来的)。
(1)革兰氏染色的一些图片分享

革兰氏染色试剂套装@青岛海博

染色片

染色要点

冲洗后的染色片
(1)含铁牛奶培养基暴烈发酵试验。最好用18*180的管子,因为产气能冲很高,真的很剧烈。

发酵过后的图片分享(这还是相对比较温和的时候,时间越长,菌初始量越多越汹涌。)
(2)卵黄琼脂培养试验。这个是用来做卵磷脂酶试验的,从FTG中挑菌液有时候需要往下和多挑一些,因为我开始从皿上接种过去以及从FTG里取1环,结果皿上接过去的菌长了,也有现象了(乳白色浑浊)。而FTG里挑的菌液没发生现象。后来多挑一些菌液现象就出现了,所以这里挑菌液时候要往下点并且多挑一点点。
(3)厌氧条件的模拟和比较。
我们实验室微生物实验设备相对比较齐全,加上个人对微生物学有极其浓厚的兴趣,所以后续进行了厌氧操作箱,厌氧盒,三气培养箱和厌氧产气袋的实验比较。然后发现了4种培养方式有所不同,为了推荐后来人做实验需要,特写一下各自优劣。
目前厌氧培养方式有厌氧盒、厌氧罐、厌氧袋+厌氧产气袋等方法。厌氧袋+厌氧产气袋法应用最普遍,适合量大实验,有价廉物美的特点。厌氧盒+厌氧产气袋法也不错,用盒代替了厌氧袋。厌氧罐抽气换气法:需要配备抽气换气装置;厌氧手套箱:比较昂贵。
首选厌氧盒,因为只做这个实验的话,厌氧盒密封性较好,能较长时间的维持厌氧环境。缺点是贵了一点。在我们国情之下,厌氧盒和对应的进口产气包还是相对比较贵的。尤其有大量实验时,需要买数个厌氧盒,估计提出申请购买时老板早抽你了。
其次厌氧产气袋,质量方面比厌氧盒要次一点,因为是软包装,就像香烟一样,软包装总比硬盒子要低一个档次一样,但是好处是量大实惠,好用不贵。所以应付大量实验时更合适。
厌氧操作箱,方便安全,和厌氧盒一样,需要购买设备,如果同时开展多个厌氧检测项目,可考虑购买。如果厌氧项目较少,买设备就不那么经济了。也就是说东西很好,有钱就上。
三气培养箱,我不知道别家三气培养箱什么情况,我家的三气培养箱氧浓度最低最低只能达到2%,下不去了。所以做不到严格厌氧,长产气荚膜梭菌没问题,但阴性菌艰难梭菌就长不起来了。

(4)动力-硝酸盐实验结果图片分享。

现象很明显:无动力,沿穿刺线生长;硝酸盐还原,滴加硝酸盐还原试剂(现用现配)后很快(几分钟内)显红色。
7.方法的不足之处
经过反复实验以及查阅文献和参考老师们的培训,总结出GB 8538-2016国标方法的几点不足:
(一)SPS培养效果和菌的回收率没有TSC高,也就是说SPS培养基不如TSC。实际检测数量就会变少。
(二)倾注平板法没有提及覆盖的问题,如无覆盖,菌为浅黄或发白颜色,不变黑。如果检测实际样品就可能造成漏检。

(1)无覆盖,划线分离法,36℃厌氧,24h。产气荚膜梭菌划线在SPS平板上基本无黑色菌落。
(1)无覆盖,划线分离法,36℃厌氧,24h。产气荚膜梭菌划线在TSC平板上有少部分黑色菌落。

(2)有覆盖,倾注平板法,36℃厌氧,24h。产气荚膜梭菌倾注 SPS 平板,覆盖后,绝大多数是黑色菌落。
注意“产气荚膜梭菌倾注SPS平板覆盖后”培养的图片,中间有手指状一个黑色区域,那是因为倾注前菌已经加了许久,造成再怎么用力已经无法把菌全部混散,这是平板计数法时候大家要注意的问题,特意选择这张图以示说明和告诫:加完菌液就要混匀,且力量要适当,否则容易沉底、蔓延、成坨。
(2)有覆盖,倾注平板法,36℃厌氧,24h。产气荚膜梭菌倾注TSC平板,覆盖后,绝大多数是黑色菌落。
从SPS和TSC平板比较来看,相同浓度菌液,产气荚膜梭菌再TSC上生长要比SPS更黑(上图2个就是同一稀释度下平皿,多次实验均如此),另一方面 TSC 上菌的数量可能比SPS 多一些(这一点还需自己和实验的同仁继续多做实验来验证。目前实验次数不够多,不能妄下结论),但有一点可以肯定也已经被大家写进文章发表了,那就是覆盖更能选择出黑色菌落,不覆盖单纯从颜色来选择菌落会漏检甚至检不到。
(三)含铁牛奶培养基配制描述信息过少,使用新鲜全脂牛奶加硫酸亚铁配制,灭菌条件设为115℃,5min为宜,放置在灭菌锅中央为好。灭完尽快取出冷却。
(四)GB 8538-2016中选择卵磷酸酶实验并不完全够用。
三月底在北京实验助手举办的培训课上,听了何艳玲老师培训课,何老师说“乳糖-明胶试验”代替“卵磷脂分解试验”的原因:部分巴氏梭菌(C.baratii)在含铁牛奶培养基中也呈现“暴烈发酵”现象,但可以用乳糖明胶试验加以区分;另外一些产气荚膜梭菌卵磷脂酶能力较弱,可能会造成假阴性,受益良多。
(五)产气荚膜梭菌发酵葡萄糖,乳糖,麦芽糖,和蔗糖,产酸产气,这个菌虽厌氧,但不是苛性的,这几点需要注意,在大肠菌群实验初发酵产酸产气,复发酵不产酸产气时就有是产气荚膜梭菌在搞事情,不妨再按照产气荚膜梭菌检测方法检测一下,就当练习一下技巧吧。
8.后记
为什么想写这个文章,因前一段时间我们单位扩项,增加了GB 8538-2016《食品安全国家标准 饮用天然矿泉水检验方法》58产气荚膜梭菌的项目,同时由于之前接触较少,在方法验证时走了不少弯路, 同时也“浪费”了一些时间(福祸相依的道理,弯路也有好处,可以把这个方法和这个菌弄的更明白一些)。后查阅文献和利用自己所学的微生物学知识进行了一些实验摸索,一部分弄明白了,一部分和标准不一致的地方也克服困难跨越过去了,获得的一些心得体会。今年3月份有幸受实验助手之邀,获得了参加其和检科院合办的3月份“北京食品安全国家标准微生物学检验技术高级学习班”的培训学习,再次见到了崇拜的野兽老师、初次见到了检科院的何老师,听他们二人分别讲解产气荚膜梭菌的检验(野兽老师讲GB 8538-2016.58 产气荚膜梭菌,何老师讲解 GB 4789.13-2012 的产气荚膜梭菌 ),发现自己的摸索获得的一些教训、经验、观点和他们很多地方不谋而合。一时间相见恨晚,说明有条件时候去参加培训很有必要,另一方面也证明自己的工作没有白干,自我探索精神也很重要。
弄明白了2个方法里面产气荚膜梭菌的实验方法以及其优劣和标准的一些暗坑。特意写出来分享给大家,让大家能够在进行这个实验项目时不至于掉坑里,让广大一线微生物检测员能够在技术水平上走的更远。让检测数据更准确可靠。熟练掌握一门实验技术,有时候可以自我陶醉一下的,往大了说,微生物检测员就是食品安全的战士,站好岗可以让人民生活更有保障(至少检测合格了不担心吃坏肚子)。

上一篇:12种非饮用水水质检测标准汇总!(包括锅炉、工业、实验用水等)
下一篇:创伤弧菌检验标准操作程序



